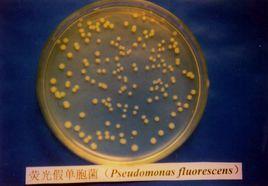
黃鏈菌 黃鏈菌

細黃鏈黴菌中文學名:細黃鏈黴菌
拉丁學名:Streptomycesmicroflavus
形態特徵:鏈黴菌屬(Streptomyces)是最高等的放線菌。有發育良好的分枝菌絲,菌絲無橫隔,分化為營養菌絲、氣生菌絲、65孢子絲。孢子絲再形成分生孢子。孢子絲螺旋形,螺旋數目一般1~3圈。孢子柱形,0.8×1.3~1.7微米。基內菌絲體玳瑁黃風帆黃色。孢子絲和孢子的形態、顏色因種而異,是分種的主要識別性狀之一。孢子絲直、柔曲。孢子卵圓形。菌落無色、微黃色、淺棕色或秸草色,色素不滲透。氣絲粉紅色、粉白色。
高氏澱粉瓊脂上氣生菌絲體白至杏仁黃色,孢子成熟時粉紅髮紫。基內菌絲體玳瑁黃風帆黃色。可溶性色素微染。孢子絲和孢子的形態、顏色因種而異,是分種的主要識別性狀之一。孢子絲直、柔曲。孢子卵圓形。菌落無色、微黃色、淺棕色或秸草色;色素不滲透。氣絲粉紅色、粉白色。
克氏合成1號瓊脂、察氏瓊脂、澱粉銨鹽瓊脂:氣絲粉紅色或粉紅秸草色,毛狀和粉狀。基絲好,無色或略微黃色、秸草色、淺棕色或微黃褐色。無可溶色素。
魚瓊脂:氣絲灰粉色,絨狀。基絲豐茂,暗棕色或微污棕色。可溶色素褐色、黑褐色。
馬鈴薯瓊脂、馬鈴薯塊:氣絲好,粉紅色,毛狀。基絲豐茂,褐栗色。可溶色素褐色、黑褐色。
明膠液化。牛奶腖化慢。澱粉水解。纖維素上不生長。蔗糖不轉化。硝酸鹽不還原。產生類黑色素、酪氨酸酶和H2S。利用葡萄糖、半乳糖、麥芽糖、甘露糖、甘露醇;弱利用蔗糖、棉子糖、肌醇;不利用阿拉伯糖、乳糖、鼠李糖、菊糖、山梨醇、衛矛醇。抑制革蘭氏陽性細菌、根瘤菌。
生態分布:已報導的有千餘種,主要分布於土壤中。
經濟用途:產生紡錘菌素;產生螺旋黴素,對革蘭氏陽性及陰性細菌、酵母菌、絲狀真菌都有抑制作用。常用於農業上防病保苗;同時可作菌肥,能轉化土壤中氮磷元素提高土壤肥力,並有刺激作物生長作用。